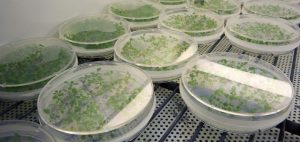

ELÉCTRICOS
Boilers, Calentadores de agua
GAS
Boilers, Calentadores de agua
SISTEMAS HÍBRIDOS
Boilers, Calentadores de agua
SOLARES
Boilers, Calentadores de agua
ESPECIALES
Fabricación a la medida, Boilers, Calentadores de agua
RECIRCULACIÓN DE AGUA CALIENTE
Boilers
CALDERAS
Boilers, Calentadores de agua
PISCINAS, ALBERCAS
Calentadores, Boilers, Calentadores de agua
RESISTENCIAS
Para calentamiento de agua de inmersión
TERMOTANQUES Y TANQUES
Boilers, Calentadores de agua
ACCESORIOS Y CONTROL
Agua caliente
BOMBAS DE CALOR - HEAT PUMP
CALENTADORES DE AGUA
RAYPAK
Boilers, Calentadores de agua
EEMAX
Boilers, Calentadores de agua
MASSTERCAL
Boilers, Calentadores de agua industriales
HUMIDIFICADORES
Nebulizadores, Pulverizadores
DESHUMIDIFICADORES
Condensación, Desecantes
CONTROL DE HUMEDAD UNIDADES - EQUIPOS
Humidificador y Deshumidificador todo en uno
CONTROL TEMPERATURA Y HUMEDAD
Equipos todo en uno
GRAFICADORES Y MEDICIÓN
Humedad y Temperatura
ACCESORIOS Y CONTROL
INFORMACIÓN TÉCNICA
NEBULIZACIÓN PARA CAPTACIÓN DE POLVOS
ELÉCTRICOS
Boilers, Calentadores de agua
GAS
Boilers, Calentadores de agua
SISTEMAS HÍBRIDOS
Boilers, Calentadores de agua
SOLARES
Boilers, Calentadores de agua
ESPECIALES
Fabricación a la medida, Boilers, Calentadores de agua
RECIRCULACIÓN DE AGUA CALIENTE
Boilers
CALDERAS
Boilers, Calentadores de agua
PISCINAS, ALBERCAS
Calentadores, Boilers, Calentadores de agua
RESISTENCIAS
Para calentamiento de agua de inmersión
TERMOTANQUES Y TANQUES
Boilers, Calentadores de agua
ACCESORIOS Y CONTROL
Agua caliente
BOMBAS DE CALOR - HEAT PUMP
CALENTADORES DE AGUA
RAYPAK
Boilers, Calentadores de agua
EEMAX
Boilers, Calentadores de agua
MASSTERCAL
Boilers, Calentadores de agua industriales
HUMIDIFICADORES
Nebulizadores, Pulverizadores
DESHUMIDIFICADORES
Condensación, Desecantes
CONTROL DE HUMEDAD UNIDADES - EQUIPOS
Humidificador y Deshumidificador todo en uno
CONTROL TEMPERATURA Y HUMEDAD
Equipos todo en uno
GRAFICADORES Y MEDICIÓN
Humedad y Temperatura